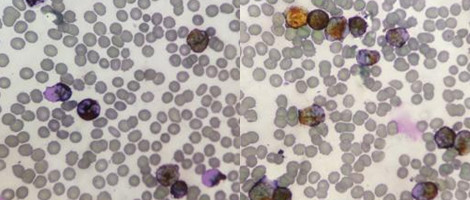

- 体检报告那么多指标,医生怎么看?
0评论2018-10-23

- 【检验临床面对面】血小板相差大,该信谁?
0评论2018-10-23

- 红细胞异常发育形态评价共识:难点问题
0评论2018-10-22

- 遇到这种情况,脑脊液怎么分检?
0评论2018-10-22

- 【检验临床面对面】尿蛋白阴性,哪来的这么多管型?
0评论2018-10-22

- 如果检验结果被质疑,你该怎么办?
0评论2018-10-21

- 【检验临床面对面】幼儿发热、腹泻,是谁在作怪?
0评论2018-10-19

- 【检验临床面对面】AST、ALT底物耗尽现象的识别及防范
0评论2018-10-18

- 【检验临床面对面】善变的“钾”面——一例血清钾假性升高引发的深度思考
0评论2018-10-17

- 化验单上很多人遗漏的细节,你注意到了吗?
0评论2018-10-17

- 这样的血常规结果能直接签发吗?
0评论2018-10-16
- 【检验临床面对面】这么高的白细胞,你见过吗?
0评论2018-10-16

- 如何留取宝宝嘘嘘样本?
0评论2018-10-15

- 【检验临床面对面】看看药物对白细胞的影响有多大
0评论2018-10-13

- 尿酸出现负值如何报告病人结果?
0评论2018-10-12

- 【检验临床面对面】这也能引起白细胞异常升高,要注意了
0评论2018-10-11

- 【检验临床面对面】临检与微生物室一次“完美”的合作
0评论2018-10-11

- 【检验临床面对面】新生儿血常规不涂片,NO!
0评论2018-10-09

- 临床微生物实验室分枝杆菌操作指南中有关核酸扩增技术的建议
0评论2018-10-09

- 【检验临床面对面】一则异常的APTT案例
0评论2018-10-08